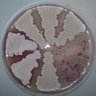
Strep_papers's profile picture. Twitterbot of #Streptomyces papers in #Pubmed
created and curated by @paulhoskisson

Brain Devpt Papers
@BrainDev_Papers
twitterbot for #CorticalThickness #SurfaceArea #DTI #Neuroimaging #cognition papers related to #humanBrainDevelopment (curated from #PubMed) by @shaili3
You might like
Lactoferrin intake from maternal milk during the neonatal hospitalization and early brain development among preterm infants dlvr.it/T18pPf

Alterations in attentional processing in youth with misophonia: A phenotypical cross-comparison with anxiety patients dlvr.it/T178nL
GABAergic inhibition shapes behavior and neural dynamics in human visual working memory dlvr.it/T15zkG
GABAergic inhibition shapes behavior and neural dynamics in human visual working memory dlvr.it/T15phN

A diffusion tensor imaging comparison of white matter development in nonsyndromic craniosynostosis to neurotypical infants dlvr.it/T0yqVD

Magnetic resonance imaging techniques for indirect assessment of myelin content in the brain using standard T1w and T2w MRI sequences and postprocessing analysis dlvr.it/T0wBRt

Selective short-term memory impairment for verbalizable visual objects in children with Developmental Language Disorder dlvr.it/T0t9pT
Variability in the age of schooling contributes to the link between literacy and numeracy in Côte d'Ivoire dlvr.it/T0srng
Associations between early trajectories of amygdala development and later school-age anxiety in two longitudinal samples dlvr.it/T0kXDZ

Effects of multiple anesthetic exposures on rhesus macaque brain development: a longitudinal structural MRI analysis dlvr.it/T0YTwf

Cerebral perfusion differences are linked to executive function performance in very preterm-born children and adolescents dlvr.it/T0XmYY
Maternal Pre-Pregnancy BMI and Gestational Weight Gain Are Associated with Preschool Children's Neuropsychological Outcomes in the APrON Cohort dlvr.it/T0Xbpj
Improving Cognitive Abilities in School-Age Children via Computerized Cognitive Training: Examining the Effect of Extended Training Duration dlvr.it/T0XSnf
Maternal Diet Quality during Pregnancy Is Associated with Neonatal Brain White Matter Development dlvr.it/T0X8Qt

Characterization of dynamic patterns of human fetal to neonatal brain asymmetry with deformation-based morphometry dlvr.it/T0TTbk

Cognitive functioning in children and adolescents with depression: A systematic review and meta-analysis dlvr.it/T0SnhD
The effects of physical activity on white matter microstructure in children with overweight or obesity: The ActiveBrains randomized clinical trial dlvr.it/T0R4c9
The effects of physical activity on white matter microstructure in children with overweight or obesity: The ActiveBrains randomized clinical trial dlvr.it/T0R3lR

United States Trends
- 1. Epstein 872K posts
- 2. Steam Machine 46.2K posts
- 3. Virginia Giuffre 50.9K posts
- 4. Bradley Beal 4,485 posts
- 5. Boebert 37K posts
- 6. Jake Paul 3,537 posts
- 7. Valve 31.5K posts
- 8. Xbox 63.4K posts
- 9. Rep. Adelita Grijalva 18.2K posts
- 10. Anthony Joshua 2,644 posts
- 11. Clinton 105K posts
- 12. GabeCube 3,242 posts
- 13. Dana Williamson 5,229 posts
- 14. Scott Boras 1,083 posts
- 15. #dispatch 54.9K posts
- 16. Dirty Donald 17.9K posts
- 17. H-1B 104K posts
- 18. Michigan State 9,722 posts
- 19. Clippers 8,549 posts
- 20. Jameis 10.6K posts
Something went wrong.
Something went wrong.